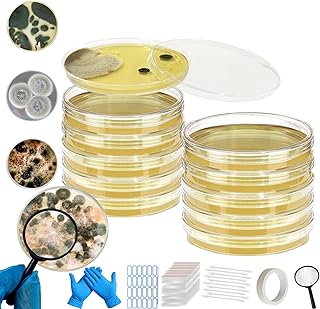
Mold Test Kit for Home,Mold Test Kit with 10 Indoor Mold air Test, Mold Detector for Home,Rapid Lab-Accurate Detection for Air & Surface Mold in Basements, Bathrooms & HVAC Systems

Cheese is a beloved dairy product enjoyed by many, but what happens when it gets mouldy? Is it safe to cut off the mould and eat the rest? The answer is... it depends. While some types of mouldy cheese can be safely consumed after removing the mouldy parts, others should be discarded entirely. The key factors to consider are the type of cheese and the extent of mould growth. Hard, dense cheeses like Parmesan or aged Cheddar can usually be salvaged by scraping off the mould, while soft cheeses like Brie or ricotta should be discarded if mouldy, as the roots are likely to have penetrated deeper into the cheese. Ultimately, while mould plays an integral role in the cheesemaking process, not all moulds are safe to eat, and it's always better to err on the side of caution when it comes to food safety.
| Characteristics | Values |
|---|---|
| Is cheese mould safe to eat? | Mouldy cheese, like other mouldy foods, should be discarded. However, some people choose to cut off the mouldy part and eat the rest. This is generally safe for hard cheeses, but not for soft cheeses. |
| How to prevent mouldy cheese | Store cheese in special cheese paper, parchment paper, or wine fridges. Consume fresh cheese within a reasonable time frame. Harder, aged cheeses are less likely to mould. |
| Health risks of eating mouldy cheese | Most moulds are not toxic, but they can negatively impact flavour and texture. Some moulds can cause allergic reactions, foodborne illnesses, or respiratory issues. In rare cases, mould can produce mycotoxins, which are poisonous and potentially deadly. |
| Types of cheese with mould | Blue cheese, Brie, Camembert, and Gorgonzola are examples of cheeses with mould. |
Explore related products
What You'll Learn

Mouldy cheese: to eat or not to eat?
Mouldy cheese is a common problem, and it can be tempting to cut off the mouldy part and eat the rest. But is it safe? Well, it depends.
Firstly, it's important to understand that mould is an integral part of the cheesemaking process. Most cheeses owe their distinct flavour and texture to the action of mould, bacteria, and other microorganisms on the proteins and sugars present in milk. So, in a sense, all cheese is mould!
However, not all moulds are the same, and some can be harmful. The key factors to consider are the type of cheese and the type of mould. For fresh, soft cheeses like ricotta, mascarpone, or chèvre, it's best to discard the entire product if mould is present, as the damp environment means the mould has likely penetrated deep into the cheese. Even if it's not toxic, it will negatively impact the flavour. For other soft cheeses like Brie or Port Salut, a quarter-inch should be cut away from any surface where mould is visible. Harder, aged cheeses like Parmesan or aged Cheddar are denser, so mould growth is usually more localized, and it's generally safe to scrape away the mouldy part and consume the rest.
It's important to note that while mould itself may not be toxic, it can indicate the presence of harmful bacteria. Some moulds can cause allergic reactions, respiratory problems, or foodborne illnesses. Therefore, it's always a risk to consume mouldy cheese, and it's generally recommended to discard any cheese that is heavily mouldy, smells of ammonia, or is both mouldy and wet.
To prevent cheese from moulding, proper storage is key. Wrap cheese in special cheese paper or parchment paper, label it with the type and purchase date, and store it in the crisper drawer of your refrigerator. Alternatively, a dedicated wine fridge can provide optimal temperature and humidity conditions for cheese storage.
Cheese and Guinea Pigs: A Healthy Treat?
You may want to see also

How to prevent mould on cheese
Mouldy cheese is not toxic, and it will rarely make you sick. However, it will likely taste bad, and it can negatively impact the flavour and texture of the cheese. To prevent mould from growing on your cheese, follow these steps:
Choose the Right Cheese
Cheeses that have been aged for 18 months or longer are the least likely to mould. Long-aged, hard cheeses like Parmesan, pecorino, aged gouda, and older cheddars are good options. These cheeses have low moisture content, so mould will barely be able to penetrate the surface. On the other hand, soft, fresh cheeses like mozzarella, ricotta, mascarpone, and chèvre are more susceptible to mould growth and should be consumed shortly after purchase.
Store Cheese Properly
When storing cheese, it is essential to minimise its exposure to air and moisture. Always reseal the cheese as tightly and completely as possible after opening. You can use a vacuum sealer or wrap the cheese tightly in plastic wrap, cheese storage paper, or parchment paper. Then, add a layer of aluminium foil for extra protection. If your cheese comes in a vacuum-sealed package, place a dry piece of paper towel on the cut edge before resealing it in a zip bag. You can also invest in a reusable cheese storage bag.
Handle Cheese with Care
Avoid touching the cheese with your bare hands, as trace amounts of bacteria can transfer from your hands and encourage mould growth. Instead, use food preparation gloves or plastic wrap as a barrier when handling the cheese. Only slice off the amount of cheese you need and keep the rest wrapped until you need more.
Cheese and Sex Drive: A Tasty Aphrodisiac?
You may want to see also

What type of mould is safe to eat?
It is generally advised that if you see mould on your food, you should throw it away. While some moulds are safe to eat, it is impossible to tell which are safe and which are harmful without testing them. Therefore, it is always best to be cautious and avoid eating mouldy food.
That being said, some foods are meant to be mouldy, and it is safe to eat them. For example, blue cheese gets its taste and appearance from a mould related to the strain used to make penicillin. Some salamis also have a characteristic thin, white mould coating that is safe to consume. In Latin America, the Caribbean, and Africa, sweet plantains are fried once the banana turns black and grows a little bit of mould on it.
When it comes to cheese, it is important to note that mould is an integral part of the cheesemaking process. Most cheeses owe their distinct deliciousness and texture to the microbiological alchemy that occurs when mould, bacteria, and other microorganisms feast on the proteins and sugars present in milk. However, fresh cheeses that are meant to be consumed shortly after they are made, such as mozzarella, ricotta, cream cheese, and queso fresco, should be discarded if mould is visible. For harder cheeses, such as Parmesan or aged cheddar, it may be safe to cut off the mouldy part and consume the rest of the cheese.
It is important to note that some moulds can cause allergic reactions and respiratory problems, and some can produce mycotoxins, which are poisonous substances that can make people sick. Therefore, it is always best to be cautious and avoid eating mouldy food whenever possible.
Cheese for Muscle Gain: Friend or Foe?
You may want to see also
Explore related products

How to identify and remove mould from cheese
Mould is an integral part of the cheesemaking process. While most moulds won't kill you, they can negatively impact the flavour and texture of the cheese.
How to identify mould on cheese
Mould on cheese will look like a fuzzy coating or white spots. If the cheese is meant to have mould, like blue cheese, it will be a similar colour and texture to the existing mould. If you see mould on a cheese that isn't supposed to have it, like mozzarella or ricotta, it's best to throw it away.
How to remove mould from cheese
If you see mould on a hard cheese like Parmesan or cheddar, you can cut off the mouldy part and eat the rest of the cheese. Cut about an inch around and below the mouldy spot to be sure you've removed all of the mould.
For soft cheeses like cream cheese or Brie, it's best to throw away the cheese if it develops mould, as mould can penetrate deeper into its structure. However, you can try removing the mould with white vinegar. Dampen a clean cloth with white vinegar, gently wipe away the mouldy spots, and let the cheese air dry before re-wrapping it. Freezing cheese is another way to prevent mould growth.
Cheese: Friend or Foe in the Bedroom?
You may want to see also

The role of mould in the cheesemaking process
Mould plays a significant role in the cheesemaking process, and in many ways, it can be said that cheese is mould. The distinct deliciousness and texture of most cheeses are owed to the microbiological alchemy that occurs when mould, bacteria, and other microorganisms feed on the proteins and sugars present in milk, transforming them into a wide range of flavourful compounds.
The type of cheese matters when it comes to mould. Fresh cheeses, such as mozzarella, ricotta, queso fresco, and other similar varieties, are meant to be consumed shortly after production and typically do not undergo the same moulding process as aged cheeses.
For harder, aged cheeses, like Parmesan, pecorino, aged cheddar, or gouda, mould can generally be scraped off without impacting the flavour or texture of the cheese. These cheeses have low moisture content, which inhibits the growth of mould roots, keeping them from penetrating deep into the cheese.
On the other hand, soft cheeses, such as Brie or Camembert, are more susceptible to mould growth due to their higher moisture content. These cheeses often develop a thick coating of white mould, which is integral to their flavour and texture. However, if other types of mould appear on these cheeses, it is recommended to cut away a portion of the cheese to ensure the removal of any potentially harmful mould.
While most moulds on cheese are not toxic, they can negatively impact the flavour and texture. Therefore, it is essential to store cheese properly and consume it within a reasonable timeframe to prevent mould growth.
Cheese: A Natural Remedy for Shaking and Dizziness?
You may want to see also
Frequently asked questions
Cheese mould is usually not toxic, but it can negatively impact the flavour and texture of the cheese. In rare cases, mould can cause allergic reactions and respiratory problems.
Harder, aged cheeses like Parmesan, pecorino, aged Gouda, or aged Cheddar can have mould scraped off and be safely eaten. Soft cheeses like Brie or Port Salut should have at least a quarter of an inch cut away from any surface where mould is visible.
Fresh soft cheeses like mozzarella, ricotta, mascarpone, chèvre, or cream cheese should be discarded if mould is visible, as the damp environment means the mould has likely penetrated deep into the cheese. Any mouldy cheese that smells of ammonia or is both mouldy and wet should be thrown away.